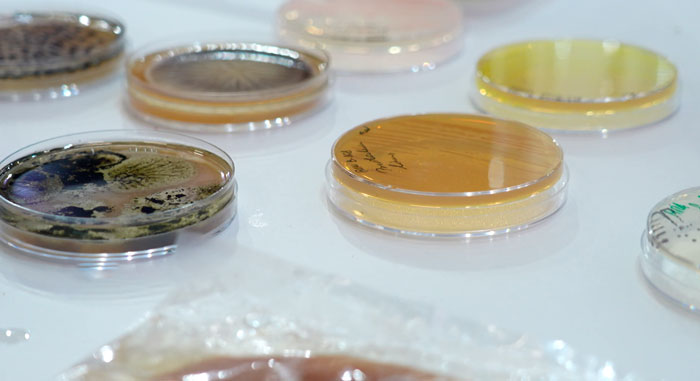
НАН Беларуси продемонстрировала потенциал микробиологии на выставке «Моя Беларусь»

Молодые, талантливые и искренне любящие свою страну. 63 представителя Гродненской области удостоены стипендии Белорусского фонда мира. Премия ежегодно присуждается одаренным учащимся и студентам, рассказали в программе Новости «24 часа» на СТВ.
63 представителя Гродненской области стали стипендиатами Белорусского фонда мира


Стипендиаты добились выдающихся результатов в научной, общественной, культурной и спортивной деятельности. Среди них – активисты волонтерского и патриотического движений. Эти молодые люди ценят возможности, которые предоставляет государство для их развития, и вносят вклад в построение нашего будущего. Организаторы подчеркивают: одаренную молодежь необходимо поддерживать, в том числе финансово. Ведь именно талантливая молодежь – золотой фонд страны.

Варвара Хваль, учащаяся гимназии №1 Ивья:
Я занимаюсь воздушной гимнастикой, еще занимаюсь танцами. Я очень сильно радовалась, мама тоже за меня порадовалась, папа тоже.

Умая Самаравира, студентка Гродненского государственного медицинского университета:
Я была очень рада, что я получила стипендию. Я участвовала в олимпиадах, делала много научных работ и учусь хорошо.

Иван Колбаско, председатель правления Гродненского областного отделения Белорусского фонда мира:
Это не просто отличники учебы, это не просто победители соревнований или каких-то творческих конкурсов. Это в первую очередь патриоты своей страны. От них будет зависеть будущее нашей страны, поэтому мы к этому относимся очень трепетно.
Стипендия Белорусского фонда мира вручается с 2003 года. В Гродненской области за это время ею отмечены более 2,5 тысячи учащихся и студентов.